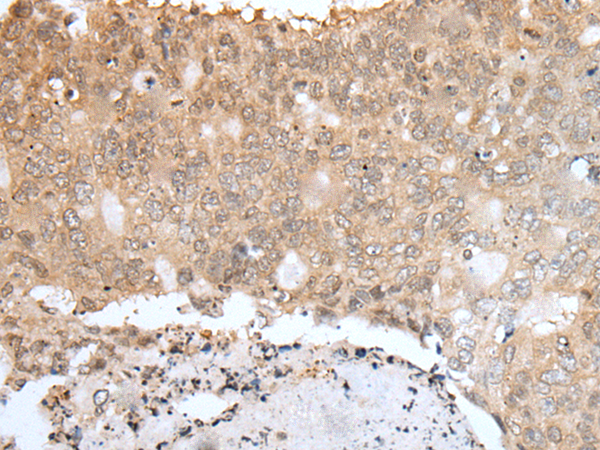

中文名稱 : 兔抗UBA5多克隆抗體
技術(shù)規(guī)格
|
Background: |
This gene encodes a member of the E1-like ubiquitin-activating enzyme family. This protein activates ubiquitin-fold modifier 1, a ubiquitin-like post-translational modifier protein, via the formation of a high-energy thioester bond. Two alternatively spliced transcript variants encoding distinct isoforms have been found for this gene. A pseudogene located on chromosome 1 has also been identified. |
|
Applications: |
ELISA, IHC |
|
Name of antibody: |
UBA5 |
|
Immunogen: |
Fusion protein of human UBA5 |
|
Full name: |
ubiquitin-like modifier activating enzyme 5 |
|
Synonyms: |
THIFP1; UBE1DC1 |
|
SwissProt: |
Q9GZZ9 |
|
ELISA Recommended dilution: |
5000-10000 |
|
IHC positive control: |
Human esophagus cancer and human colorectal cancer |
|
IHC Recommend dilution: |
25-100 |
購物車
幫助
021-54845833/15800441009
